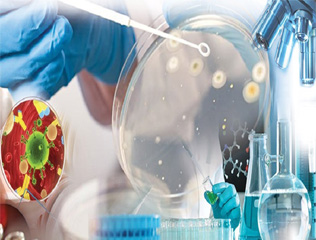

Welcome To QAS...
Established in the year 2022. QAS Analytical Services Pvt. Ltd. (QAS) is a professional body providing to provide Testing, Method development, Method Validation, Analytical services and consultancy services for industrial products enabling them to acquire different standard certifications. With our expertise and services we have been catering to various manufacturers, commercial and service sectors comprising of analytical testing services of material, pharmaceutical products, ayurvedic products, water, food products and many other services like chemical testing, microbiological services and others.
Our Values
Customers:- We are committed to building the loyalty of our customers and ensuring that the satisfaction of their needs is central to everything we do.
Employees:- We are committed to creating an environment where we can take pride in ourselves, our colleagues and company.
Vision
QAS is dedicated to providing truth of their products, generating sets for its customers by QAS team, empowered by a culture of trust and caring.
MISSION
To build & maintain a strong faith for QAS by delivering to its customers a professional service that is always fair, efficient, helpful and responsive.
Contact
Want to get in touch? We’d love to hear from you.Here’s how you can reach us…
Head Office
7 & 8C, Mahavir Marg, Gandhi Nagar,
Indore-453112 (M.P.), India.
Email Us
qaslabs@qaslabs.com
info.qas22@gmail.com
Call Us
0731-2991814, 7879823006, 9098709927